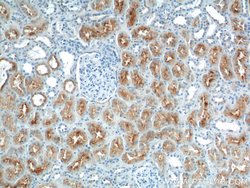
LRP2 Rabbit anti-Human, Polyclonal, Proteintech 150 &mu;L; Unconjugated:Antibodies,

Learn More
LRP2 Rabbit anti-Human, Polyclonal, Proteintech


Rabbit Polyclonal Antibody
Supplier: Proteintech Group Inc 197001AP150UL

Description
This antibody is specific to LRP2 and detects endogenous LRP2 with an apparent molecular weight 280 kDa, which is smaller than the predicted molecular weight (522 kDa) and probably represent a proteolytic fragment of the large glycoprotein.
The protein encoded by this gene, low density lipoprotein-related protein 2 (LRP2) or megalin, is a multi-ligand endocytic receptor that is expressed in many different tissues but primarily in absorptive epithilial tissues such as the kidney. This glycoprotein has a large amino-terminal extracellular domain, a single transmembrane domain, and a short carboxy-terminal cytoplasmic tail. The extracellular ligand-binding-domains bind diverse macromolecules including albumin, apolipoproteins B and E, and lipoprotein lipase. The LRP2 protein is critical for the reuptake of numerous ligands, including lipoproteins, sterols, vitamin-binding proteins, and hormones. This protein also has a role in cell-signaling; extracellular ligands include parathyroid horomones and the morphogen sonic hedgehog while cytosolic ligands include MAP kinase scaffold proteins and JNK interacting proteins. Recycling of this membrane receptor is regulated by phosphorylation of its cytoplasmic domain. Mutations in this gene cause Donnai-Barrow syndrome (DBS) and facio-oculoacoustico-renal syndrome (FOAR).Specifications
| LRP2 | |
| Polyclonal | |
| Unconjugated | |
| LRP2 | |
| DBS, Fx1a, Glycoprotein 330, gp330, LRP 2, LRP2, Megalin | |
| Rabbit | |
| Antigen Affinity Chromatography | |
| RUO | |
| 4036 | |
| -20°C | |
| Liquid |
| Flow Cytometry, Immunohistochemistry (Paraffin), Western Blot | |
| 0.32 mg/mL | |
| PBS with 50% glycerol and 0.02% sodium azide; pH 7.3 | |
| P98164 | |
| LRP2 | |
| Peptide | |
| 150 μL | |
| Primary | |
| Human | |
| Antibody | |
| IgG |
The Fisher Scientific Encompass Program offers items which are not part of our distribution portfolio. These products typically do not have pictures or detailed descriptions. However, we are committed to improving your shopping experience. Please use the form below to provide feedback related to the content on this product.